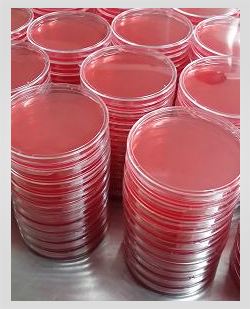
PCA平板_平板计数琼脂(PCA)

万千商家帮你免费找货
0 人在求购买到急需产品
- 详细信息
- 文献和实验
- 技术资料
- 库存:
100
- 英文名:
平板计数琼脂(PCA)
- 保质期:
6个月
- 供应商:
上海烜雅生物科技有限公司
- 保存条件:
2-8℃
- 规格:
20
【产品名称】 PCA平板_平板计数琼脂(PCA)
【规格】 90mm
【用途】 一种通用的培养基,适用于各种微生物的培养,环境检测
【贮藏】 低温干燥避光
【配方】 请直接问我司客服索取
【其他用途】 供实验室检测用,其他用途请咨询销售人员
【用法】 详见说明书
【保质期】来电详询
PCA平板_平板计数琼脂(PCA)现货供应,江浙沪隔天到货,外地3-5天到货。部分产品接受定制。
【分装】
将制配制好的培养基分装到适当的容器中,根据不同用途,容器的体积可为培养基的1倍、2倍或3倍。
【质控示例】
3、灵敏度测试(35℃或25℃培养 检验标准:生长率≥70%)
| 质控菌株 | 生长率 | 结论 |
| 大肠埃希氏菌CMCC(B)44102 | 93% | 合格 |
| 金黄色葡萄球菌CMCC(B)26003 | 92%,产黄色色素 | 合格 |
| 铜绿假单胞菌CMCC(B)10104 | 101%,产绿色色素 | 合格 |
| 枯草芽孢杆菌CMCC(B)63501 | 96% | 合格 |
| 黑曲霉CMCC(F)98003 | 89%,产黑色菌丝 | 合格 |
| 白色念珠菌CMCC(F)98001 | 93% | 合格 |
PCA平板_平板计数琼脂(PCA)特点:
◆伽玛射线辐照灭菌
Gamma irradiatec
◆三层无菌包装
Three layers sterile packing
◆符合USP/EP/ChP标准
Accord with USP/EP/ChP
◆如发现涨袋,请勿带入清洁区
If the bag swelled,please do not take it into clear area

【注意事项】
1. 取样人员于取样前检査琼脂平皿。不能使用已被微生物污染的平皿。
2.使用后的培养基应进行消毒处理。
3.本产品使用方法非强制性,如用户有具体参考资料可进行相应调整。
4.在方法确认阶段,应对培养基、培养时间和培养温度等进行评估,以确定适于环境中代表性微生物的最佳培养条件。
烜雅生物专业经营PCA平板_平板计数琼脂(PCA), 产品深受广大客户喜爱,我公司经营至今实行三包原则:保证产品质量,保证产品效果,保证产品售后。
PCA平板_平板计数琼脂(PCA)相关产品:
| Cary-Blair 氏运送培养基キャリー・ブレア氏輸送培地Cary-Blair Transport Medium |
| Stuart 运送培养基スチューアト輸送培地Stuart Transport Medium |
| Amies 运送培养基(含活性碳)アミー輸送培地Amies Transport Medium with carbon |
| 改良运送培养基 変法輸送培地Modified Transport Medium |
| 溴紫蛋白胨培养液グルコースペプトン培養液Bromcresol Purple Peptone Culture Colution |
| 标准Ⅰ号营养琼脂 標準普通寒天Ⅰ号 Standared Ⅰ Nutrient Agar |
| 标准Ⅰ号营养琼肉汤 標準普通ブイヨンⅠ号 Standared Ⅰ Nutrient Broth |
| 标准Ⅱ号营养琼脂 標準普通寒天Ⅱ号 Standared Ⅱ Nutrient Agar |
| m-TGE 肉汤m-TGE ブイヨンm-TGE Broth |
| AC 肉汤AC ブイヨンAC Broth |
| 2216E 液体培养基2216E ブイヨン2216E Broth |
| 胰蛋白胨大豆肉汤(TSB)トリプトソーヤブイヨンTrypticase Soy Broth |
| Dey/Engley 中和肉汤基础D/E 中和ブイヨン基础Dey/Engley Neutralizing Broth Base |
| Dey/Engley 中和琼脂基础D/E 中和寒天基础Dey/Engley Neutralizing Agar Base |
| 缓冲蛋白胨水(BPW)緩衝ペプトン水Buffered Peptone Water |
风险提示:丁香通仅作为第三方平台,为商家信息发布提供平台空间。用户咨询产品时请注意保护个人信息及财产安全,合理判断,谨慎选购商品,商家和用户对交易行为负责。对于医疗器械类产品,请先查证核实企业经营资质和医疗器械产品注册证情况。
文献和实验在生物实验中相信大家都经常要倒平板,细菌培养,分子生物学实验等等。医药企业中倒平板更是家常便饭,环境监测、水监测、微生物检查等,初学者往往都倒不好,我们总结几点小技巧供大家参考。 一、防止倒皿时的冷凝 有经验的都知道,手心不烫手背烫,这是一个经验数据,此时的温度在 45 度左右,最适合倒平板。 如果要连续倒多个皿,尤其是在冬天往往容易凝固,一旦凝固则需要再加热到较高温度才能融化(玻璃体的特性)。所以建议此时有个 50 度的恒温水浴开着,随时把装培养基的三角
vera21173 我研究的是一个基因对肿瘤细胞增殖的影响,上调这个基因的表达可以促进细胞增殖(CCK-8和平板集落形成实验的结果一致),下调这个基因的表达可以抑制细胞增殖。但有平板集落形成实验有一个奇怪的现象,稳转这个基因的细胞集落形成数量明显比空载细胞多,但集落大小比空载细胞小很多,镜下观察发现空载细胞形成的集落中的细胞很分散,而稳转目的基因的细胞集落中细胞很紧密。请问这能说明什么问题? zhouyongchun_1
材料与试剂 以布氏杆菌病平板凝集反应为例。 1 .玻璃板、刻度吸管等。 2 .布氏杆菌平板凝集抗原、布氏杆菌标准阳性血清。 操作方法 1 .取洁净玻板一块,用玻璃铅笔划成方格,并注明待检血清号码。 2 .取0 . 2 ml 吸管分别吸取 0.08ml 、 0.04ml 、 0.02ml 和 0.01ml 各放入一方
技术资料暂无技术资料 索取技术资料